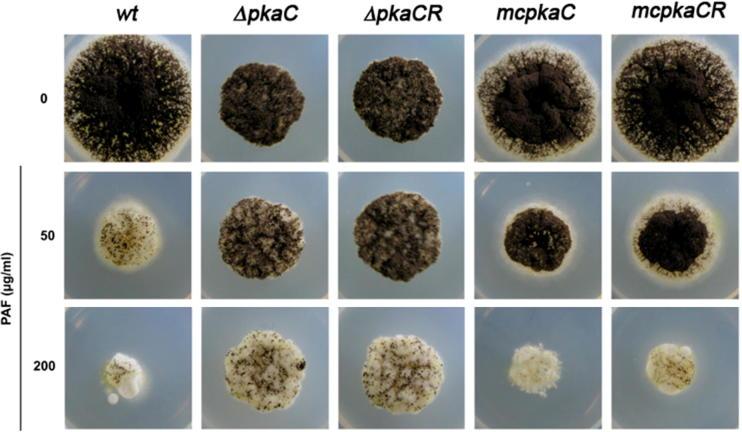
https://cdn.ncbi.nlm.nih.gov/pmc/blobs/8521/4424949/c293b6520fb8/gr1.jpg

Protein kinase A signaling and calcium ions are major players in PAF mediated toxicity against Aspergillus niger.
作者信息
Binder Ulrike, Benčina Mojca, Fizil Ádám, Batta Gyula, Chhillar Anil K, Marx Florentine
机构信息
Biocenter, Division of Molecular Biology, Medical University of Innsbruck, Innrain 80, A-6020 Innsbruck, Austria; Division of Hygiene and Medical Microbiology, Schöpfstrasse 41, Medical University of Innsbruck, A-6020 Innsbruck, Austria.
Department of Biotechnology, National Institute of Chemistry, Hajdrihova 19, SI-1000 Ljubljana, Slovenia.
出版信息
FEBS Lett. 2015 May 8;589(11):1266-71. doi: 10.1016/j.febslet.2015.03.037. Epub 2015 Apr 14.
The Penicillium chrysogenum antifungal protein PAF is toxic against potentially pathogenic Ascomycetes. We used the highly sensitive aequorin-expressing model Aspergillus niger to identify a defined change in cytoplasmic free Ca(2+) dynamics in response to PAF. This Ca(2+) signature depended on an intact positively charged lysine-rich PAF motif. By combining Ca(2+) measurements in A. niger mutants with deregulated cAMP/protein kinase A (PKA) signaling, we proved the interconnection of Ca(2+) perturbation and cAMP/PKA signaling in the mechanistic function of PAF. A deep understanding of the mode of action of PAF is an invaluable prerequisite for its future application as new antifungal drug.